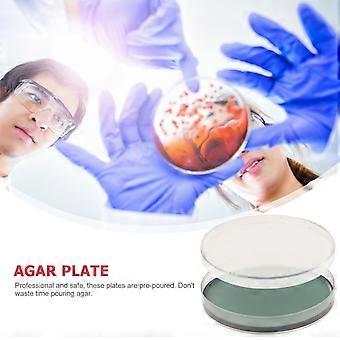

Nutrient Agar Plates for Science Experiment 5Pcs Portable Agar Petri Dishes
और मुफ़्त शिपिंग
Nutrient Agar Plates for Science Experiment 5Pcs Portable Agar Petri Dishes
- ब्रांड: Unbranded

Nutrient Agar Plates for Science Experiment 5Pcs Portable Agar Petri Dishes
- ब्रांड: Unbranded
| मूल्य: |
स्टॉक में है
हम निम्नलिखित भुगतान विधियाँ स्वीकार करते हैं
विवरण
- ब्रांड: Unbranded
- श्रेणी: पेट्री डिश
-
रंग: As Shown 1
-
आकार: 9.00X9.00X1.20CM
- Fruugo ID: 428794589-900948658
- EAN: 3202704078133
उत्पाद सुरक्षा जानकारी
कृपया नीचे दी गई इस उत्पाद से संबंधित विशिष्ट उत्पाद सुरक्षा जानकारी देखें
निम्नलिखित जानकारी इस उत्पाद को बेचने वाले स्वतंत्र तृतीय-पक्ष खुदरा विक्रेता द्वारा प्रदान की गई है।
उत्पाद सुरक्षा लेबल

डिलीवरी और वापसी
2 दिनों के भीतर भेजा जाएगा
-
STANDARD: मुफ़्त - के बीच वितरण गुरु 06 नवंबर 2025–गुरु 13 नवंबर 2025 - मुफ़्त
चीन से शिप हो रहा है।
हम आपके द्वारा ऑर्डर किए गए उत्पादों को पूरी तरह से और आपके विनिर्देशों के अनुसार डिलीवर करने की पूरी कोशिश करते हैं। हालाँकि, यदि आपको अधूरा ऑर्डर या आपके ऑर्डर से कोई अलग आइटम प्राप्त होता है या किसी अन्य कारण से यदि आप अपने ऑर्डर से संतुष्ट नहीं हैं तो आप ऑर्डर या ऑर्डर में शामिल कोई भी उत्पाद वापस कर सकते हैं और आइटम के लिए पूर्ण रिफ़ंड प्राप्त कर सकते हैं। सम्पूर्ण वापसी पॉलिसी दिखाएँ
उत्पाद अनुपालन विवरण
कृपया नीचे दी गई इस उत्पाद से संबंधित विशिष्ट अनुपालन जानकारी देखें।
निम्नलिखित जानकारी इस उत्पाद को बेचने वाले स्वतंत्र तृतीय-पक्ष खुदरा विक्रेता द्वारा प्रदान की गई है।
निर्माता:
नीचे Fruugo पर बिक्री किए जाने वाले संबंधित उत्पाद निर्माता के संपर्क विवरण की जानकारी संबधी सूचना है।
- Shenzhen Woyingpei Trade Co., Ltd.
- Shenzhen Woyingpei Trade Co., Ltd.
- shen zhen shi nan shan qu yue hai jie dao ke ji yuan she qu ke zhi xi lu 1 hao ke yuan xi 23 dong bei 2101
- Shenzhen
- CN
- 518000
- mnvasfafaa@hotmail.com
- 19925352422
यूरोपीय संघ(EU) में जिम्मेदार व्यक्ति:
नीचे यूरोपीय संघ में जिम्मेदार व्यक्ति की संपर्क जानकारी संबंधी सूचना है। जिम्मेदार व्यक्ति यूरोपीय संघ में स्थित पदनामित आर्थिक ऑपरेटर है जो यूरोपीय संघ में बिक्री किए जाने वाले संबंधित उत्पाद संबंधी अनुपालन दायित्वों के लिए जिम्मेदार है।
- EC REP SERVICES SL
- EC REP SERVICES SL
- Calle Gran Via 49, 7 Dch.
- Madrid
- ES
- 28013
- ecrepservice@hotmail.com
- 0034 910 5631 02